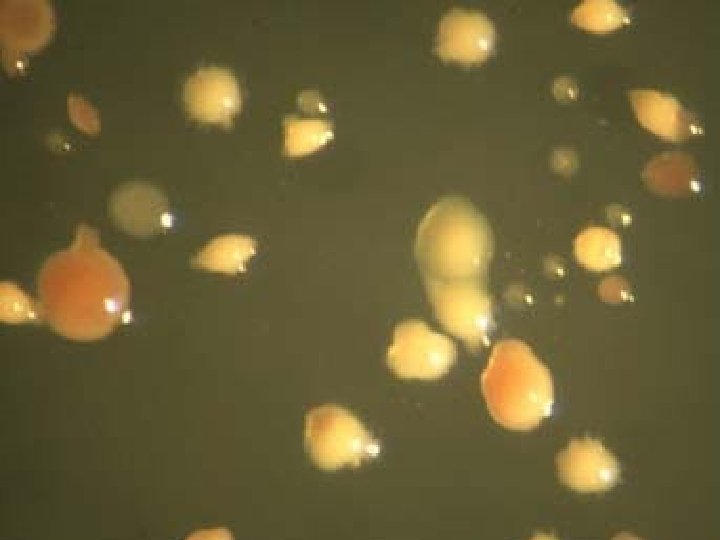

THE SIX KINGDOMS OF LIVING THINGS Part 1



















![Halophiles – live in very salty water [halite is rock salt] (Dead Sea) (evaporation Halophiles – live in very salty water [halite is rock salt] (Dead Sea) (evaporation](https://slidetodoc.com/presentation_image/37eb4d61aeee2ebea6ed95c0956fbe1f/image-20.jpg)

![Three types: • [1] Spheres (cocci) Three types: • [1] Spheres (cocci)](https://slidetodoc.com/presentation_image/37eb4d61aeee2ebea6ed95c0956fbe1f/image-37.jpg)




![• [2] Rods (bacilli) • [2] Rods (bacilli)](https://slidetodoc.com/presentation_image/37eb4d61aeee2ebea6ed95c0956fbe1f/image-42.jpg)







![• [3] Spirals (spirilli) • [3] Spirals (spirilli)](https://slidetodoc.com/presentation_image/37eb4d61aeee2ebea6ed95c0956fbe1f/image-50.jpg)



















- Slides: 69
THE SIX KINGDOMS OF LIVING THINGS
Part 1 • Archaebacteria • Eubacteria • Protista
PROKARYOTES & EUKARYOTES
PROKARYOTES • Archaebacteria (prokaryotes “Without nucleus”) • Lack any internal membrane-bound structures • Smallest single-celled organisms on Earth
EUKARYOTES • “True nucleus” • Found in all living things except bacteria • Have many kinds of internal membranebound structures • Have a nucleus where DNA is located
(1) Archaebacteria • • • “Archae” = “Ancient” (≥ 3 b. y. ) Prokaryotes (“before nucleus”) Small, single-celled Live where other living things cannot Need no oxygen or sunlight Make food from chemosynthesis, other chemicals, such as H 2 S
Different groups: • Methanogens – make methane
Methanogens: methane-producing bacteria
Methanopyrus
Methosarcina
Thermophiles – live in very hot water (hot springs) (underwater geothermal vents)
Thermus aquaticus Yellowstone N. P.
Underwater geothermal vents (“black smokers”) discovered - 1976
Ecology of deep thermal vents • Hot, mineral-rich water spews out • Mixes with cold ocean water • Supplies energy, raw materials
Halophiles – live in very salty water [halite is rock salt] (Dead Sea) (evaporation ponds)
Great Salt Lake – halophiles turn the land red after floods
Acidophiles – live in highly acid water (acid lakes)
Alkalaiphiles – live in highly alkaline water (Mono Lake, California) (Lake Eyre, Australia)
Cyanobacteria • Earliest photosynthesizers • Changed Earth’s early atmosphere from reducing to oxidizing Stromatolites Shark’s Bay Australia
(2) Eubacteria (“true” bacteria) • Live in soil, water, human bodies • Germs – harmful (cause sickness, diseases) • Beneficial bacteria – a. used to make yogurt, cheese, etc. • • • Typically 40 million/gram soil 1 million/m. L fresh water 5 x 1030 bacteria on Earth Form much of Earth’s biomass. Approx. 10 x as many bacteria as human cells in the body.
Three types: • [1] Spheres (cocci)
Staphylococcus epidermidis
Methicillin-resistant Staphylococcus aureus (MRSA)
Meningitis
Pneumonia
• [2] Rods (bacilli)
Escherichia coli
Bubonic Plague
Tuberculosis
Anthrax
Tetanus
Typhoid Fever
Ulcers
• [3] Spirals (spirilli)
Syphilis
Lyme Disease
Leptospirosis (200 x)
• First described by Adolf Weil in 1886 • “Acute infectious disease with enlargement of spleen, jaundice and nephritis". • First observed in 1907 from a post-mortem renal tissue slice. 1908 – Inada and Ito first identified it as the causative organism; 1916 – noted its presence in rats. • World's most common disease transmitted to people from animals • Rare in humans. • Commonly transmitted to humans by allowing water that has been contaminated by animal urine to come in contact with unhealed breaks in skin, eyes, or mucous membranes.
Useful bacteria • Bacterial fermentation of milk → yogurt • Bacteria, enzymes turn milk into cheese • Lactic acid bacteria turn cabbage into sauerkraut • Bacterial fermentation turns cucumbers into pickles • Bacteria turn alcohol in wine into vinegar.
• Other foods made by bacteria: – Sourdough breads, pretzels – Olives – Soy sauce
(3) Protista • Protozoans – animal-like – Flagellates – Amoeboids – Ciliates – Sporozoans • Plantlike • Fungus-like – Slime molds, water molds
Protozoans - flagellates Giardia lamblia
Termite protozoan
Protozoans - amoeboids
Protozoans - ciliates
Plantlike protozoans Euglena
Plant-like Protists • Algae • Kelp
Fungus-like Protists • Slime molds